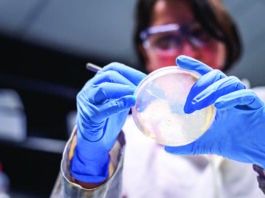
Symbolbild QIAGEN. S_1232_0_LS_GG_QIAseq_xHYB_Viral_Bacterial_Panels_Launch. Copyright Foto: QIAGEN

BIOTRONIK: CE-Zulassung für den BioMonitor 2
BIOTRONIK, ein Hersteller kardio- und endovaskulärer Medizintechnik, hat die CE-Zulassung und die Ergebnisse einer Pilotstudie zur Leistungsfähigkeit seines BioMonitor 2 bekanntgegeben
MorphoSys und Immatics mit strategischer Allianz
Die Unternehmen MorphoSys AG und Immatics Biotechnologies GmbH haben eine strategische Allianz vereinbart.
Fresenius erwartet Dividendenanstieg
Der Gesundheitskonzern Fresenius erwartet für das laufende Geschäftsjahr einen deutlichen Anstieg der Dividende.
Immatics gründet Tochtergesellschaft in den USA
Die Tübinger Immatics Biotechnologies GmbH und das University of Texas MD Anderson Cancer Center haben die Gründung von Immatics US, Inc. bekannt gegeben.
Startschuss für den Science4Life Venture Cup 2016
Ab dem 1. September können Neugründer aus den Branchen Life Sciences und Chemie ihre Ideen mit professioneller Unterstützung des Science4Life-Netzwerks zu einem wettbewerbsfähigen Businessplan entwickeln.
AdvanceCOR schließt zweite Finanzierungsrunde ab
Die Biotech-Firma AdvanceCOR aus Martinsried hat eine weitere Finanzierungsrunde mit der MIG AG, Bayern Kapital, Bio-M, dem Hightech-Gründerfonds und der KfW Bank in Höhe von 2,2 Mio. EUR abgeschlossen.
Bayer Healthcare: Grants4Apps Accelerator 2015
Knapp drei Monate lang erhalten fünf internationale Start-ups aus dem e-Health-Segment die Möglichkeit, ihre Geschäftsideen mit Unterstützung von Bayer Healthcare weiterzuentwickeln.
Ergomed: Handelsstart der Aktie auf Xetra
Das britische Unternehmen Ergomed plc, (Londoner Wertpapierbörse: ERGO oder ‘Ergomed’), das spezialisierte Dienstleistungen für die pharmazeutische Industrie anbietet und sich der Entwicklung neuer Wirkstoffe widmet, hat heute den Handelsstart der Ergomed-Aktie in Deutschland auf Xetra, der elektronischen Handelsplattform der Deutsche Börse AG, bekanntgegeben. Die ISIN ist GB00BN7ZCY67 und das Kürzel lautet 2EM GR.
SYGNIS unterzeichnet Vertriebsvereinbarung mit chinesischer Nanodigmbio
Die SYGNIS AG hat eine Vertriebsvereinbarung mit der Nanodigmbio Co. Ltd. für den Vertrieb ihres Produktportfolios in China bekanntgegeben.
WILEX AG verliert strategischen Partner
Die WILEX AG (ISIN DE000A11QVV0 / WL6 / FWB) hat die Beendigung der Zusammenarbeit des Pharma-Konzerns Roche mit der WILEX-Tochtergesellschaft Heidelberg Pharma bekanntgegeben.